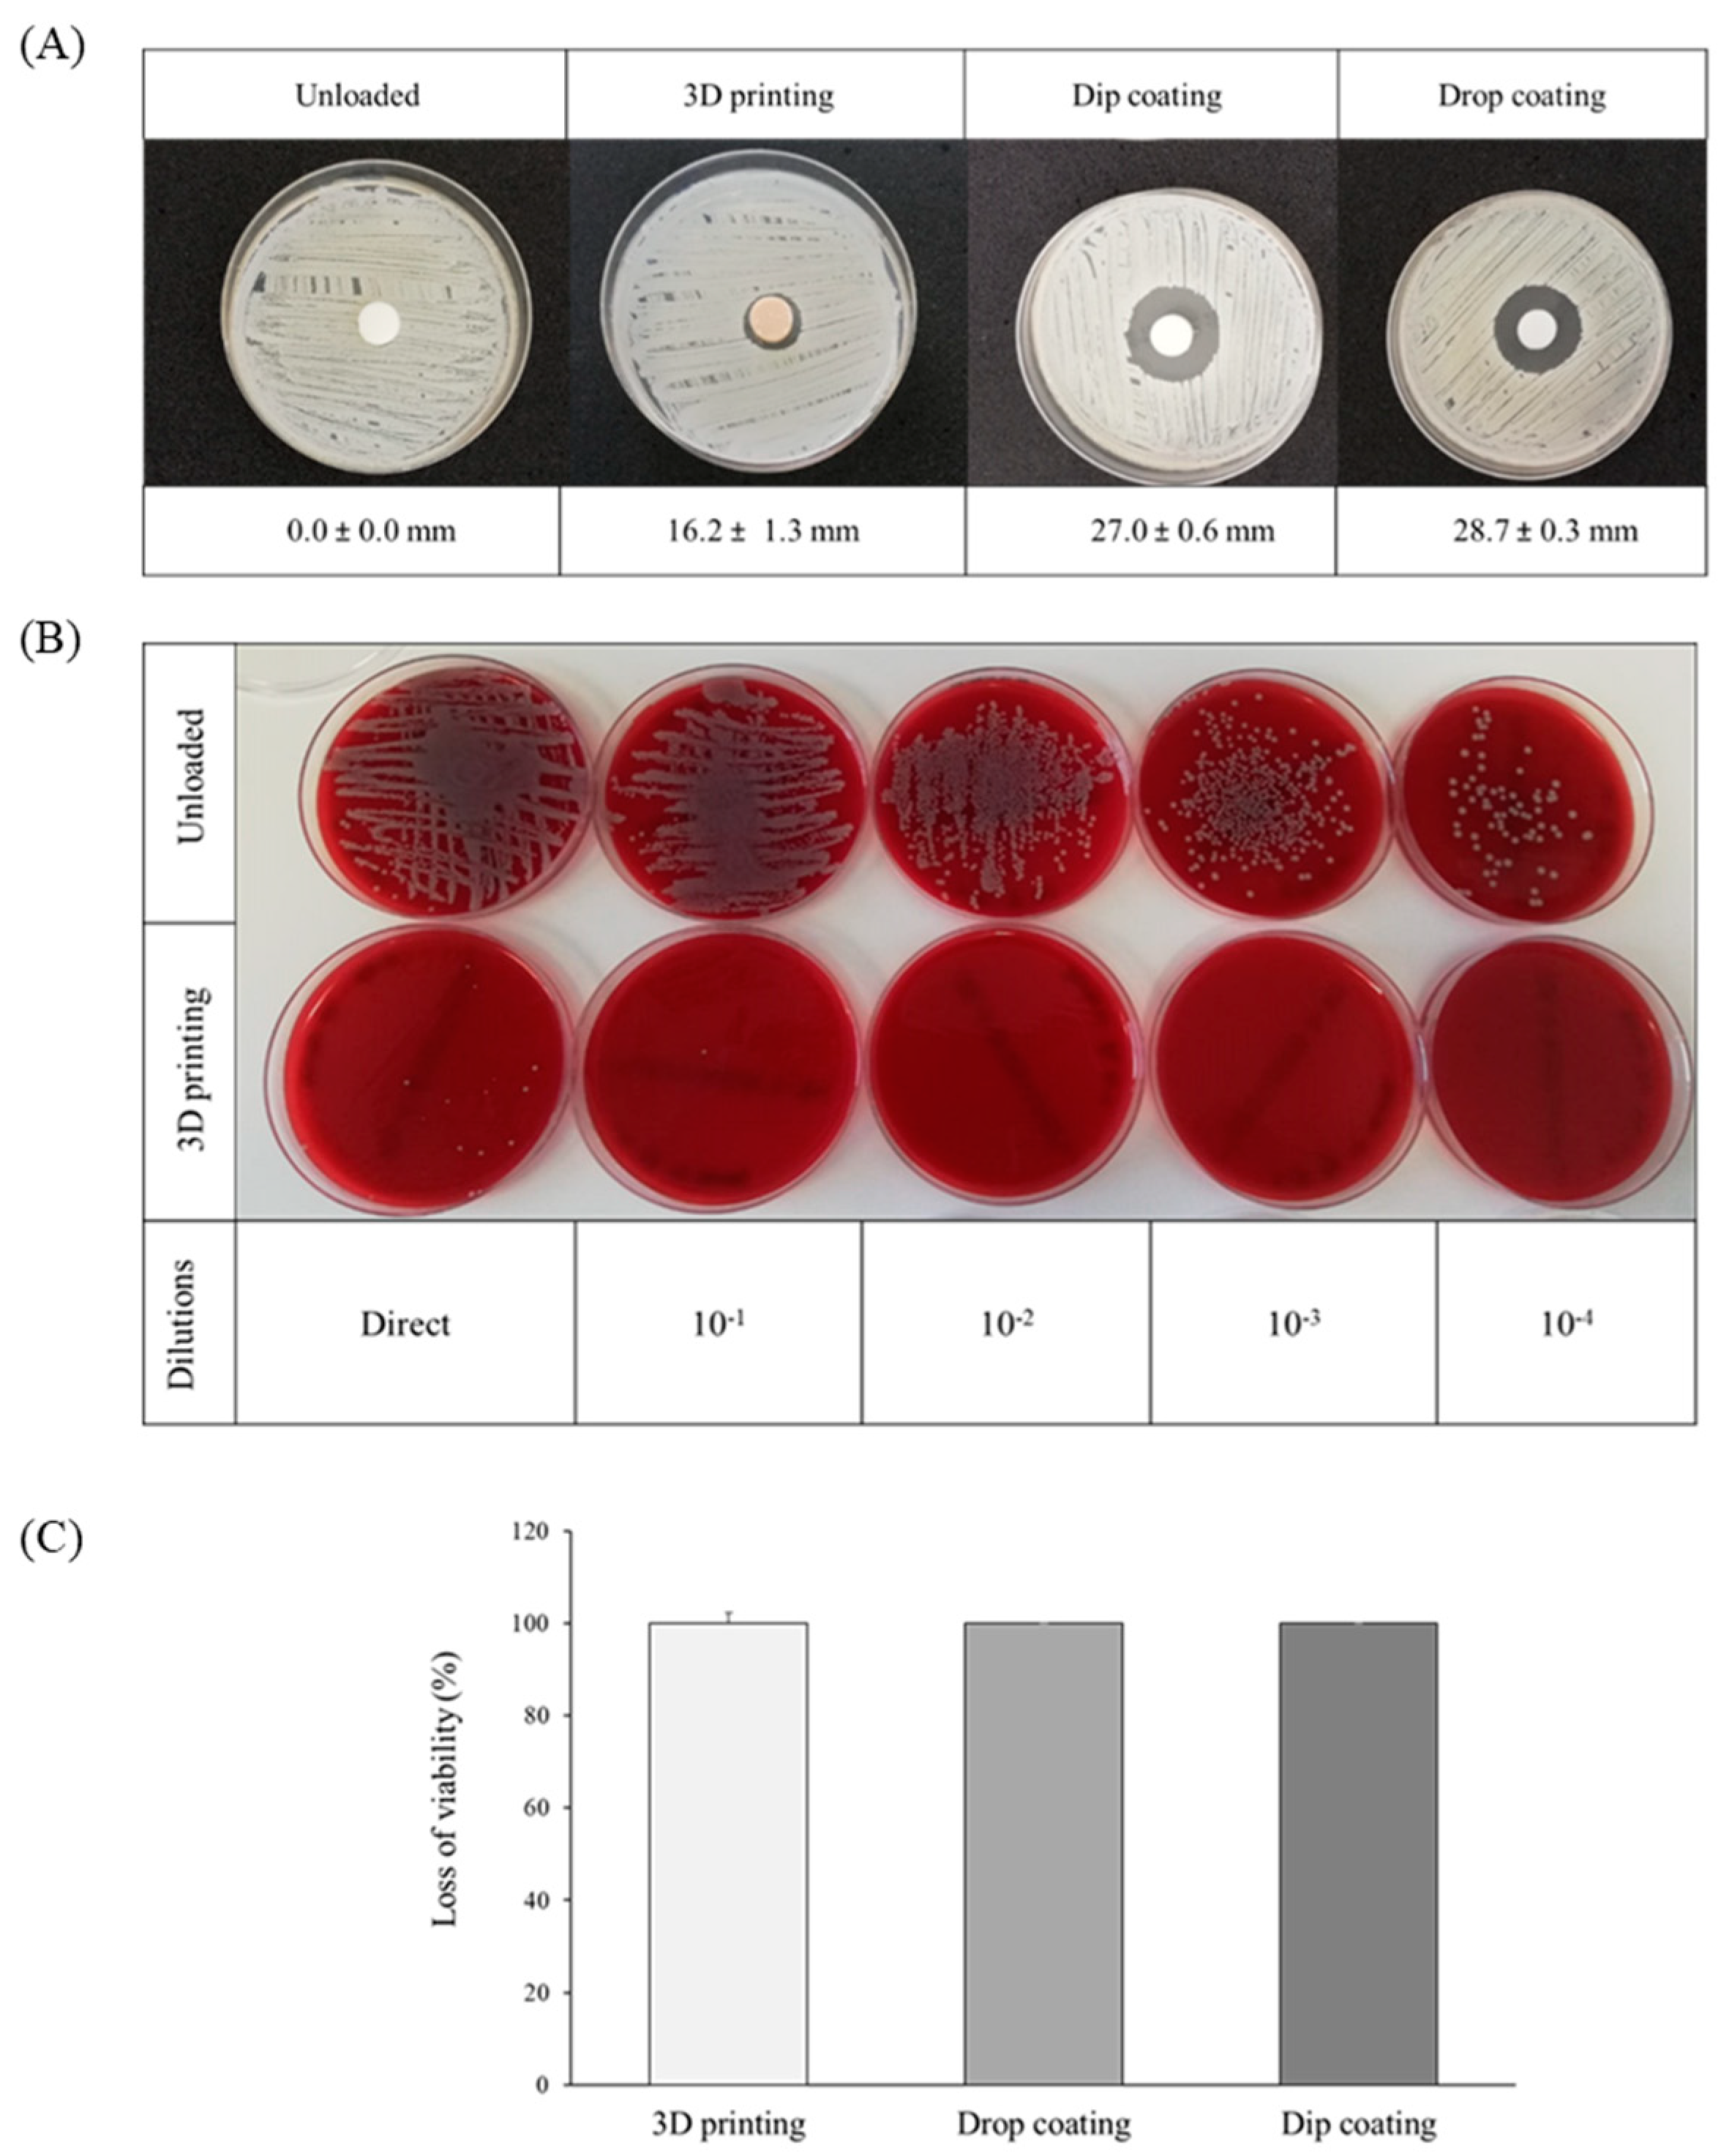
Polymers 15 04250 g003

Vancomycin-Loaded 3D-Printed Polylactic Acid–Hydroxyapatite Scaffolds for Bone Tissue Engineering
Abstract
:1. Introduction
2. Materials and Methods
2.1. 3D Printing and Vancomycin Loading
2.2. Vancomycin Release Studies
2.3. Solvent Extraction Cytotoxicity, Cell Morphology and Proliferation
2.4. Antibacterial (Diffusion, Direct Contact) and Antibiofilm Activity
2.5. Statistical Analysis
3. Results and Discussion
3.1. Vancomycin Release Kinetics
3.2. Solvent Extraction Cytotoxicity, Cell Morphology and Viability
3.3. Antibacterial and Antibiofilm Activity
4. Conclusions
Supplementary Materials
Author Contributions
Funding
Institutional Review Board Statement
Data Availability Statement
Acknowledgments
Conflicts of Interest
References
- Josyula, A.; Parikh, K.S.; Pitha, I.; Ensign, L.M. Engineering biomaterials to prevent post-operative infection and fibrosis. Drug Deliv. Transl. Res. 2021, 11, 1675–1688. [Google Scholar] [CrossRef] [PubMed]
 - Damodaran, V.B.; Bhatnagar, D.; Murthy, N.S. Biomedical Polymers Synthesis and Processing; Springer: Cham, Switzerland, 2016. [Google Scholar]
 - Fernández-Cervantes, I.; Morales, M.A.; Agustín-Serrano, R.; Cardenas-García, M.; Pérez-Luna, P.V.; Arroyo-Reyes, B.L.; Maldonado-García, A. Polylactic acid/sodium alginate/hydroxyapatite composite scaffolds with trabecular tissue morphology designed by a bone remodeling model using 3D printing. J. Mater. Sci. 2019, 54, 9478–9496. [Google Scholar] [CrossRef]
 - Zhang, H.; Mao, X.; Du, Z.; Jiang, W.; Han, X.; Zhao, D.; Han, D.; Li, Q. Three dimensional printed macroporous polylactic acid/hydroxyapatite composite scaffolds for promoting bone formation in a critical-size rat calvarial defect model. Sci. Technol. Adv. Mater. 2016, 17, 136–148. [Google Scholar] [CrossRef] [PubMed]
 - Dubinenko, G.E.; Zinoviev, A.L.; Bolbasov, E.N.; Novikov, V.T.; Tverdokhlebov, S.I. Preparation of Poly(L-lactic acid)/Hydroxyapatite composite scaffolds by fused deposit modeling 3D printing. Mater. Today Proc. 2020, 22, 228–234. [Google Scholar] [CrossRef]
 - Lambert, B.J.; Mendelson, T.A.; Craven, M.D. Radiation and Ethylene Oxide Terminal Sterilization Experiences with Drug Eluting Stent Products. AAPS PharmSciTech 2011, 12, 1116–1126. [Google Scholar] [CrossRef] [PubMed]
 - Tyler, B.; Gullotti, D.; Mangraviti, A.; Utsuki, T.; Brem, H. Polylactic acid (PLA) controlled delivery carriers for biomedical applications. Adv. Drug Deliv. Rev. 2016, 107, 163–175. [Google Scholar] [CrossRef] [PubMed]
 - Davila, S.P.; Rodríguez, L.G.; Chiussi, S.; Serra, J.; González, P. How to Sterilize Polylactic Acid Based Medical Devices? Polymers 2021, 13, 2115. [Google Scholar] [CrossRef]
 - Aguado-Maestro, I.; De Frutos-Serna, M.; González-Nava, A.; Santos, A.M.-D.; García-Alonso, M. Are the common sterilization methods completely effective for our in-house 3D printed biomodels and surgical guides? Injury 2021, 52, 1341–1345. [Google Scholar] [CrossRef]
 - Serra, T.; Timoneda, M.A.M.; Planell, J.A.; Navarro, M. 3D printed PLA-based scaffolds. Organogenesis 2013, 9, 239–244. [Google Scholar] [CrossRef]
 - Tack, P.; Victor, J.; Gemmel, P.; Annemans, L. 3D-printing techniques in a medical setting: A systematic literature review. Biomed. Eng. Online 2016, 15, 115. [Google Scholar] [CrossRef]
 - Madrid, A.P.M.; Vrech, S.M.; Sanchez, M.A.; Rodriguez, A.P. Advances in additive manufacturing for bone tissue engineering scaffolds. Mater. Sci. Eng. C 2019, 100, 631–644. [Google Scholar] [CrossRef]
 - Corcione, C.E.; Gervaso, F.; Scalera, F.; Padmanabhan, S.K.; Madaghiele, M.; Montagna, F.; Sannino, A.; Licciulli, A.; Maffezzoli, A. Highly loaded hydroxyapatite microsphere/ PLA porous scaffolds obtained by fused deposition modelling. Ceram. Int. 2019, 45, 2803–2810. [Google Scholar] [CrossRef]
 - Deligianni, D.D.; Katsala, N.D.; Koutsoukos, P.G.; Missirlis, Y.F. Effect of surface roughness of hydroxyapatite on human bone marrow cell adhesion, proliferation, differentiation and detachment strength. Biomaterials 2000, 22, 87–96. [Google Scholar] [CrossRef]
 - Anselme, K. Osteoblast adhesion on biomaterials. Biomaterials 2000, 21, 667–681. [Google Scholar] [CrossRef]
 - López-Álvarez, M.; Pérez-Davila, S.; Rodríguez-Valencia, C.; González, P.; Serra, J. The improved biological response of shark tooth bioapatites in a comparative in vitro study with synthetic and bovine bone grafts. Biomed. Mater. 2016, 11, 035011. [Google Scholar] [CrossRef]
 - Makarov, C.; Berdicevsky, I.; Raz-Pasteur, A.; Gotman, I. In vitro antimicrobial activity of vancomycin-eluting bioresorbable β-TCP-polylactic acid nanocomposite material for load-bearing bone repair. J. Mater. Sci. Mater. Med. 2013, 24, 679–687. [Google Scholar] [CrossRef] [PubMed]
 - Pérez-Davila, S.; Garrido-Gulías, N.; González-Rodríguez, L.; López-Álvarez, M.; Serra, J.; López-Periago, J.E.; González, P. Physicochemical Properties of 3D-Printed Polylactic Acid/Hydroxyapatite Scaffolds. Polymers 2023, 15, 2849. [Google Scholar]
 - Esteban, J.; Pérez-Tanoira, R.; Pérez-Jorge-Peremarch, C.; Gómez-Barrena, E. Bacterial Adherence to Biomaterials Used in Surgical Procedures. In Microbiology for Surgical Infections; Academic Press: Cambridge, MA, USA, 2014; pp. 41–57. [Google Scholar] [CrossRef]
 - Hudson, M.C.; Ramp, W.K.; Frankenburg, K.P. Staphylococcus aureus adhesion to bone matrix and bone-associated bio-materials. FEMS Microbiol. Lett. 1999, 173, 279–284. [Google Scholar] [CrossRef]
 - Anderson, M.J.; Lin, Y.-C.; Gillman, A.N.; Parks, P.J.; Schlievert, P.M.; Peterson, M.L. Alpha-Toxin Promotes Staphylococcus aureus Mucosal Biofilm Formation. Front. Cell. Infect. Microbiol. 2012, 2, 64. [Google Scholar] [CrossRef]
 - Idrees, M.; Sawant, S.; Karodia, N.; Rahman, A. Staphylococcus aureus Biofilm: Morphology, Genetics, Pathogenesis and Treatment Strategies. Int. J. Environ. Res. Public Health 2021, 18, 7602. [Google Scholar] [CrossRef]
 - Folliero, V.; Franci, G.; Dell’annunziata, F.; Giugliano, R.; Foglia, F.; Sperlongano, R.; De Filippis, A.; Finamore, E.; Galdiero, M. Evaluation of Antibiotic Resistance and Biofilm Production among Clinical Strain Isolated from Medical Devices. Int. J. Microbiol. 2021, 2021, 9033278. [Google Scholar] [CrossRef]
 - Chen, Z.-Y.; Gao, S.; Zhang, Y.-W.; Zhou, R.-B.; Zhou, F. Antibacterial biomaterials in bone tissue engineering. J. Mater. Chem. B 2021, 9, 2594–2612. [Google Scholar] [CrossRef]
 - von Eiff, C.; Jansen, B.; Kohnen, W.; Becker, K. Infections Associated with Medical Devices. Drugs 2005, 65, 179–214. [Google Scholar] [CrossRef] [PubMed]
 - Mo, X.; Zhang, D.; Liu, K.; Zhao, X.; Li, X.; Wang, W. Nano-Hydroxyapatite Composite Scaffolds Loaded with Bioactive Factors and Drugs for Bone Tissue Engineering. Int. J. Mol. Sci. 2023, 24, 1291. [Google Scholar] [CrossRef]
 - Tappa, K.; Jammalamadaka, U.; Weisman, J.A.; Ballard, D.H.; Wolford, D.D.; Pascual-Garrido, C.; Wolford, L.M.; Woodard, P.K.; Mills, D.K. 3D Printing Custom Bioactive and Absorbable Surgical Screws, Pins, and Bone Plates for Localized Drug Delivery. J. Funct. Biomater. 2019, 10, 17. [Google Scholar] [CrossRef]
 - Composición De La Operación Quirúrgica Del Hospital. Available online: https://www.freepik.es/vector-gratis/composicion-operacion-quirurgica-hospital_21078485.htm#query=surgical%20room&position=11&from_view=search&track=ais (accessed on 2 October 2023).
 - Ilustración Del Icono De La Computadora. Available online: https://www.freepik.es/vector-gratis/ilustracion-icono-computadora_2606079.htm#query=ordenador&position=31&from_view=search&track=sph (accessed on 2 October 2023).
 - Botellas Para Medicamentos Conjunto De Vectores Realistas. Available online: https://www.freepik.es/vector-gratis/botellas-medicamentos-conjunto-vectores-realistas_5900581.htm#fromView=search&term=frasco+laboratorio+con+tapa&page=1&position=34&track=ais®ularType=vector (accessed on 2 October 2023).
 - Vector De Elemento De Gota De Agua Realista. Available online: https://www.freepik.es/vector-gratis/iconos-equipo-laboratorio_3924851.htm#fromView=search&term=pipeta+de+laboratorio&page=1&position=12&track=ais®ularType=vector (accessed on 2 October 2023).
 - Vector De Elemento De Gota De Agua Realista. Available online: https://www.freepik.es/vector-gratis/vector-elemento-gota-agua-realista_16398922.htm#fromView=search&term=gota+de+agua&page=1&position=16&track=ais®ularType=vector (accessed on 2 October 2023).
 - UNE-EN ISO 10993-5:2009; Biological Evaluation of Medical Devices-Part 5: Tests for in Vitro Citotoxicity. ISO: Geneva, Switzerland, 2009.
 - UNE-EN ISO 10993-12:2021; Biological Evaluation of Medical Devices-Part 12: Sample Preparation and Reference Materials. ISO: Geneva, Switzerland, 2021.
 - Martí, M.; Frígols, B.; Serrano-Aroca, A. Antimicrobial Characterization of Advanced Materials for Bioengineering Applications. J. Vis. Exp. 2018, 138, e57710. [Google Scholar] [CrossRef]
 - Zi, C.; Zeng, D.; Ling, N.; Dai, J.; Xue, F.; Jiang, Y.; Li, B. An improved assay for rapid detection of viable Staphylococcus aureus cells by incorporating surfactant and PMA treatments in qPCR. BMC Microbiol. 2018, 18, 132. [Google Scholar] [CrossRef]
 - Díaz-Rodríguez, P.; Pérez-Estévez, A.; Seoane, R.; González, P.; Serra, J.; Landin, M. Suitability of Biomorphic Silicon Carbide Ceramics as Drug Delivery Systems against Bacterial Biofilms. ISRN Pharm. 2013, 2013, 104529. [Google Scholar] [CrossRef]
 - Chartpitak, T.; Tulakarnwong, S.; Riansuwan, K.; Kiratisin, P.; Nasongkla, N. Vancomycin-impregnated polymer on Schanz pin for prolonged release and antibacterial application. J. Drug Deliv. Sci. Technol. 2018, 47, 223–229. [Google Scholar] [CrossRef]
 - Samura, M.; Kitahiro, Y.; Tashiro, S.; Moriyama, H.; Hamamura, Y.; Takahata, I.; Kawabe, R.; Enoki, Y.; Taguchi, K.; Takesue, Y.; et al. Efficacy and Safety of Daptomycin versus Vancomycin for Bacteremia Caused by Methicillin-Resistant Staphylococcus aureus with Vancomycin Minimum Inhibitory Concentration > 1 µg/mL: A Systematic Review and Meta-Analysis. Pharmaceutics 2022, 14, 714. [Google Scholar] [CrossRef]
 - Taha, M.; Arulanandam, R.; Chen, A.; Diallo, J.; Abdelbary, H. Combining povidone-iodine with vancomycin can be beneficial in reducing early biofilm formation of methicillin-resistant Staphylococcus aureus and methicillin-sensitive S. aureus on titanium surface. J. Biomed. Mater. Res. Part B Appl. Biomater. 2023, 111, 1133–1141. [Google Scholar] [CrossRef] [PubMed]
 - Lian, X.; Liu, H.; Wang, X.; Xu, S.; Cui, F.; Bai, X. Antibacterial and biocompatible properties of vancomycin-loaded nano-hydroxyapatite/collagen/poly (lactic acid) bone substitute. Prog. Nat. Sci. Mater. Int. 2013, 23, 549–556. [Google Scholar] [CrossRef]
 - Ranganathan, S.I.; Kohama, C.; Mercurio, T.; Salvatore, A.; Benmassaoud, M.M.; Kim, T.W.B. Effect of temperature and ultraviolet light on the bacterial kill effectiveness of antibiotic-infused 3D printed implants. Biomed. Microdevices 2020, 22, 59. [Google Scholar] [CrossRef]
 - Chen, X.; Gao, C.; Jiang, J.; Wu, Y.; Zhu, P.; Chen, G. 3D printed porous PLA/nHA composite scaffolds with enhanced osteogenesis and osteoconductivity in vivo for bone regeneration. Biomed. Mater. 2019, 14, 065003. [Google Scholar] [CrossRef] [PubMed]
 - Li, J.; Li, K.; Du, Y.; Tang, X.; Liu, C.; Cao, S.; Zhao, B.; Huang, H.; Zhao, H.; Kong, W.; et al. Dual-Nozzle 3D Printed Nano-Hydroxyapatite Scaffold Loaded with Vancomycin Sustained-Release Microspheres for Enhancing Bone Regeneration. Int. J. Nanomed. 2023, 18, 307–322. [Google Scholar] [CrossRef]
 - Maikranz, E.; Spengler, C.; Thewes, N.; Thewes, A.; Nolle, F.; Jung, P.; Bischoff, M.; Santen, L.; Jacobs, K. Different binding mechanisms of Staphylococcus aureus to hydrophobic and hydrophilic surfaces. Nanoscale 2020, 12, 19267–19275. [Google Scholar] [CrossRef] [PubMed]

Disclaimer/Publisher’s Note: The statements, opinions and data contained in all publications are solely those of the individual author(s) and contributor(s) and not of MDPI and/or the editor(s). MDPI and/or the editor(s) disclaim responsibility for any injury to people or property resulting from any ideas, methods, instructions or products referred to in the content.  | 
© 2023 by the authors. Licensee MDPI, Basel, Switzerland. This article is an open access article distributed under the terms and conditions of the Creative Commons Attribution (CC BY) license (https://creativecommons.org/licenses/by/4.0/).
Share and Cite
Pérez-Davila, S.; Potel-Alvarellos, C.; Carballo, R.; González-Rodríguez, L.; López-Álvarez, M.; Serra, J.; Díaz-Rodríguez, P.; Landín, M.; González, P. Vancomycin-Loaded 3D-Printed Polylactic Acid–Hydroxyapatite Scaffolds for Bone Tissue Engineering. Polymers 2023, 15, 4250. https://doi.org/10.3390/polym15214250
Pérez-Davila S, Potel-Alvarellos C, Carballo R, González-Rodríguez L, López-Álvarez M, Serra J, Díaz-Rodríguez P, Landín M, González P. Vancomycin-Loaded 3D-Printed Polylactic Acid–Hydroxyapatite Scaffolds for Bone Tissue Engineering. Polymers. 2023; 15(21):4250. https://doi.org/10.3390/polym15214250
Chicago/Turabian StylePérez-Davila, Sara, Carmen Potel-Alvarellos, Raquel Carballo, Laura González-Rodríguez, Miriam López-Álvarez, Julia Serra, Patricia Díaz-Rodríguez, Mariana Landín, and Pío González. 2023. "Vancomycin-Loaded 3D-Printed Polylactic Acid–Hydroxyapatite Scaffolds for Bone Tissue Engineering" Polymers 15, no. 21: 4250. https://doi.org/10.3390/polym15214250
APA StylePérez-Davila, S., Potel-Alvarellos, C., Carballo, R., González-Rodríguez, L., López-Álvarez, M., Serra, J., Díaz-Rodríguez, P., Landín, M., & González, P. (2023). Vancomycin-Loaded 3D-Printed Polylactic Acid–Hydroxyapatite Scaffolds for Bone Tissue Engineering. Polymers, 15(21), 4250. https://doi.org/10.3390/polym15214250
        
